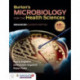
Burton's Microbiology for the Health Sciences, Enhanced Edition

Kurv
Vare
varer
(tom)
Ingen varer
Fastlægges senere
Forsendelse
0,- kr
I alt
Burton's Microbiology for the Health Sciences, Enhanced Edition
(Bog, Paperback / softback, Engelsk)
- Type: Bog
- Format: Paperback / softback
-
Sprog:
Engelsk

- ISBN-13: 9781284209952
- Se flere detaljer ▼
Bemærk: Kan ikke leveres før jul.
Beskrivelse
Emphasizing the relevance of microbiology to a career in the health professions, Burton's Microbiology for the Health Sciences provides the vital microbiology information you need to protect yourself and your patients from infectious diseases.
Læsernes anmeldelser (0)
Alle detaljer
| Forlag | Jones and Bartlett Publishers, Inc |
| Forfattere | Paul G. Engelkirk, Janet Duben-Engelkirk, Robert C. Fader |
| Type | Bog |
| Format | Paperback / softback |
| Sprog | Engelsk |
| Udgave | Eleventh Edition |
| Udgivelsesdato | 21-05-2020 |
| Første udgivelsesår | 2020 |
| Originalsprog | United States |
| Sideantal | 478 |
| Indbinding | Paperback / softback |
| Forlag | Jones and Bartlett Publishers, Inc |
| Sideoplysninger | 478 pages |
| Mål | 216 x 276 x 18 |
| ISBN-13 / EAN-13 | 9781284209952 |